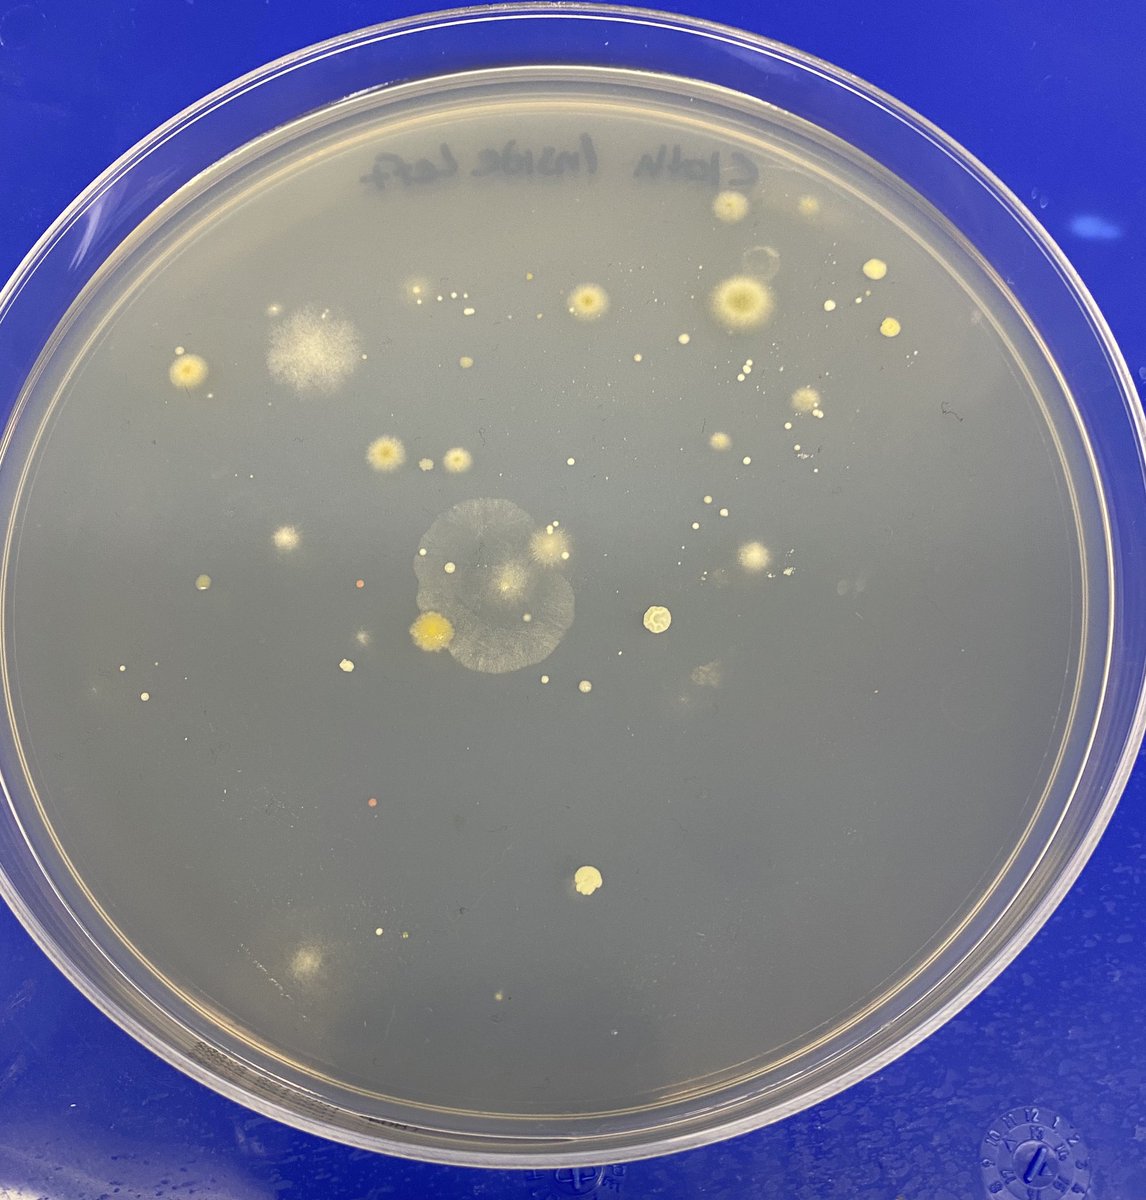
Inside and Outside of kids cloth mask worn all day at school.Plated on PDA with no selection.Central planning and it’s effect on evolution and anti-fragility?If 7B people all wear 300um filters that collect microbes, the human microbiome will change. Is this Good or bad?
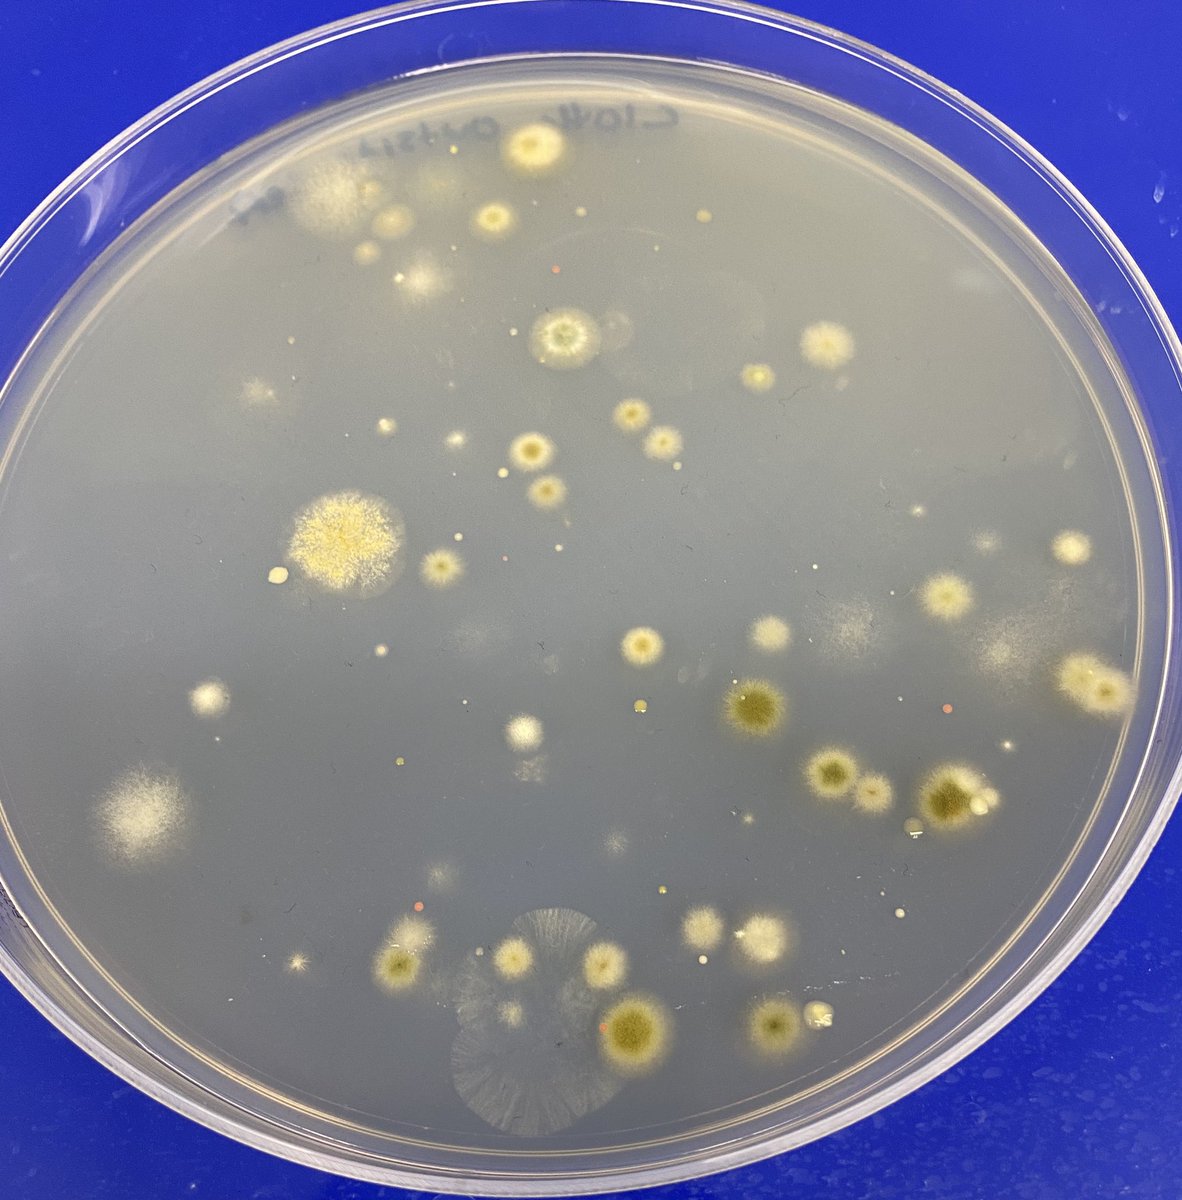
Inside and Outside of kids cloth mask worn all day at school.Plated on PDA with no selection.Central planning and it’s effect on evolution and anti-fragility?If 7B people all wear 300um filters that collect microbes, the human microbiome will change. Is this Good or bad?
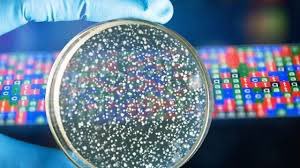
This is just the tip of the iceberg.Most microbes (~95%) we don’t know how to culture so only ~5% of the diversity shows up on PDA.In many ways Culture is just performance art or microbiome tarot cards.The cool kids sequence. https://cmr.asm.org/content/28/1/237

Inside and Outside of kids cloth mask worn all day at school.
Plated on PDA with no selection.
Central planning and it’s effect on evolution and anti-fragility?
If 7B people all wear 300um filters that collect microbes, the human microbiome will change. Is this Good or bad?
Plated on PDA with no selection.
Central planning and it’s effect on evolution and anti-fragility?
If 7B people all wear 300um filters that collect microbes, the human microbiome will change. Is this Good or bad?
In order for one to identify the microbes. ITS/16S sequencing or whole genome sequencing is required.
We describe that in these manuscripts.
https://f1000research.com/articles/5-2471
https://f1000research.com/articles/4-1422
We describe that in these manuscripts.
https://f1000research.com/articles/5-2471
https://f1000research.com/articles/4-1422
Cannabis microbiomes are relevant to the mask debate as this is the study of microbes you might inhale and thus we are particularly sensitized to fungi that can cause aspergillosis or fusariosis.
Microbes that synthesize mycotoxins are important as well.
Microbes that synthesize mycotoxins are important as well.
When immunocompromised patients get hit with Aspergillosis...
50% fatality rate.
Tad higher than C19.
Remington tracks this back to a cannabis vaporizer.
Vaporizers use nebulization to create Cannabinoid aerosols. Not hot enough to sterilize
https://www.cmaj.ca/content/187/17/1305
50% fatality rate.
Tad higher than C19.
Remington tracks this back to a cannabis vaporizer.
Vaporizers use nebulization to create Cannabinoid aerosols. Not hot enough to sterilize
https://www.cmaj.ca/content/187/17/1305
This is just the tip of the iceberg.
Most microbes (~95%) we don’t know how to culture so only ~5% of the diversity shows up on PDA.
In many ways Culture is just performance art or microbiome tarot cards.
The cool kids sequence.
https://cmr.asm.org/content/28/1/237
Most microbes (~95%) we don’t know how to culture so only ~5% of the diversity shows up on PDA.
In many ways Culture is just performance art or microbiome tarot cards.
The cool kids sequence.
https://cmr.asm.org/content/28/1/237
Sequence not only identifies the microbe but it can inform you if it has genes that synthesize mycotoxins.
Citrinin and Paxilline genes were discovered this way. These are mycotoxins found in Penicillium that can negatively impact seizure control with Cannabidiol.
Citrinin and Paxilline genes were discovered this way. These are mycotoxins found in Penicillium that can negatively impact seizure control with Cannabidiol.
You can run the exp. at your school. PDA plates can be bought from Teknova.
Just stamp your mask for a minute onto a plate. Remove mask and Seal the lid and let it grow at RT for 3-4 days.
Everyone’s will be a little different and kids can all make fun of each other’s bugs.
Just stamp your mask for a minute onto a plate. Remove mask and Seal the lid and let it grow at RT for 3-4 days.
Everyone’s will be a little different and kids can all make fun of each other’s bugs.
I would clean the masks after running the experiment..obviously.
I think teachers should engage students over this new and odd behavior we’ve mandated.
Teaching science is important but If schools fail to teach human rights, they are just indoctrination camps.
I think teachers should engage students over this new and odd behavior we’ve mandated.
Teaching science is important but If schools fail to teach human rights, they are just indoctrination camps.
@threadreaderapp unroll

 Read on Twitter
Read on Twitter